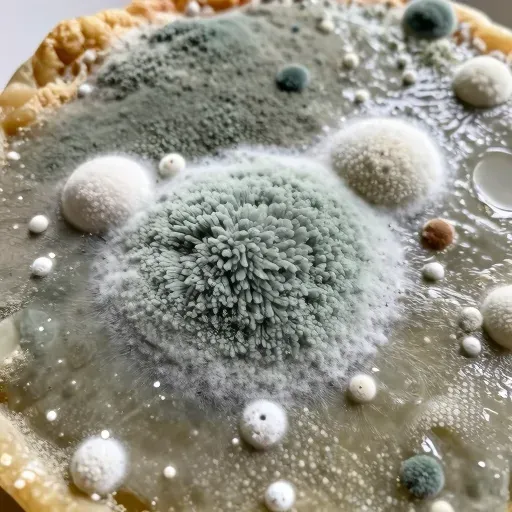
Từ vựng 霉 – Mốc, meo

霉
一丶フ丨丶丶丶丶ノ一フフ丶一丶
15
HSK1
Danh từ
Hình ảnh:

Từ ghép
Định nghĩa
1
danh từ
Nghĩa:Mốc, meo
Ví dụ (3)
面包长霉了。
Bánh mì bị mốc rồi.
雨季容易发霉。
Mùa mưa dễ bị mốc.
这股霉味很重。
Mùi mốc này rất nặng.
Từ đã xem
0 từChưa có từ nào được xem gần đây
Chưa có từ nào được xem gần đây